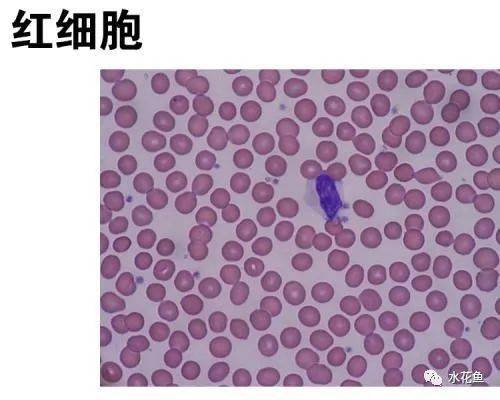
鱼类鳃隐鞭虫病体表和鳃部均无明显病症只是表现粘液较多

鳃隐鞭虫

鳃隐鞭虫
图片尺寸268x179
鳃隐鞭虫病
图片尺寸759x599
图片信息
图片尺寸794x529
鳃曳虫priapulus caudatus的形态.图片:sjoharen.com
图片尺寸640x427
鱼类寄生虫图谱(慎入,画面可能引起不适)#水产养殖技术 #水 - 抖音
图片尺寸945x863
龙鱼鳃隐鞭虫病的急救
图片尺寸2000x1500
全部图片
图片尺寸670x446
鞭虫病的概述
图片尺寸581x480
鱼类鳃隐鞭虫病体表和鳃部均无明显病症只是表现粘液较多
图片尺寸500x400
隐鞭虫(cryptobia):如鳃隐鞭虫(c.
图片尺寸220x168
龙鱼鳃隐鞭虫病的急救
图片尺寸2000x1500
病原体是寄生虫,用显微镜检查可见鳃隐鞭虫,车轮虫,指环虫,中华鳋等
图片尺寸900x560
柳癸的相册-peripatus @velvet
图片尺寸650x483
龙鱼鳃隐鞭虫病的急救
图片尺寸2000x1500
图片描述
图片尺寸953x599
file:solifugae chelicera lateral aspect 2012 01 24 0999s.jpg
图片尺寸1240x1024
这个虫子叫什么
图片尺寸600x540
你的鱼老出问题,只是你忽略了这些!
图片尺寸4000x3000![[每周一例]黄鳍鲷鱼种感染鳃隐鞭虫](https://i.ecywang.com/upload/1/img1.baidu.com/it/u=809790295,137006739&fm=253&fmt=auto&app=138&f=JPEG?w=515&h=430)
[每周一例]黄鳍鲷鱼种感染鳃隐鞭虫
图片尺寸515x430
生态鱼药与四种土法防治鱼病绿色生态无副作用来源广
图片尺寸1280x774

















![[每周一例]黄鳍鲷鱼种感染鳃隐鞭虫](https://i.ecywang.com/upload/1/img1.baidu.com/it/u=809790295,137006739&fm=253&fmt=auto&app=138&f=JPEG?w=515&h=430)

![[每周一例]黄鳍鲷鱼种感染鳃隐鞭虫](https://trna.gzlyjc.com/upload/article/2020071012085988.jpg)